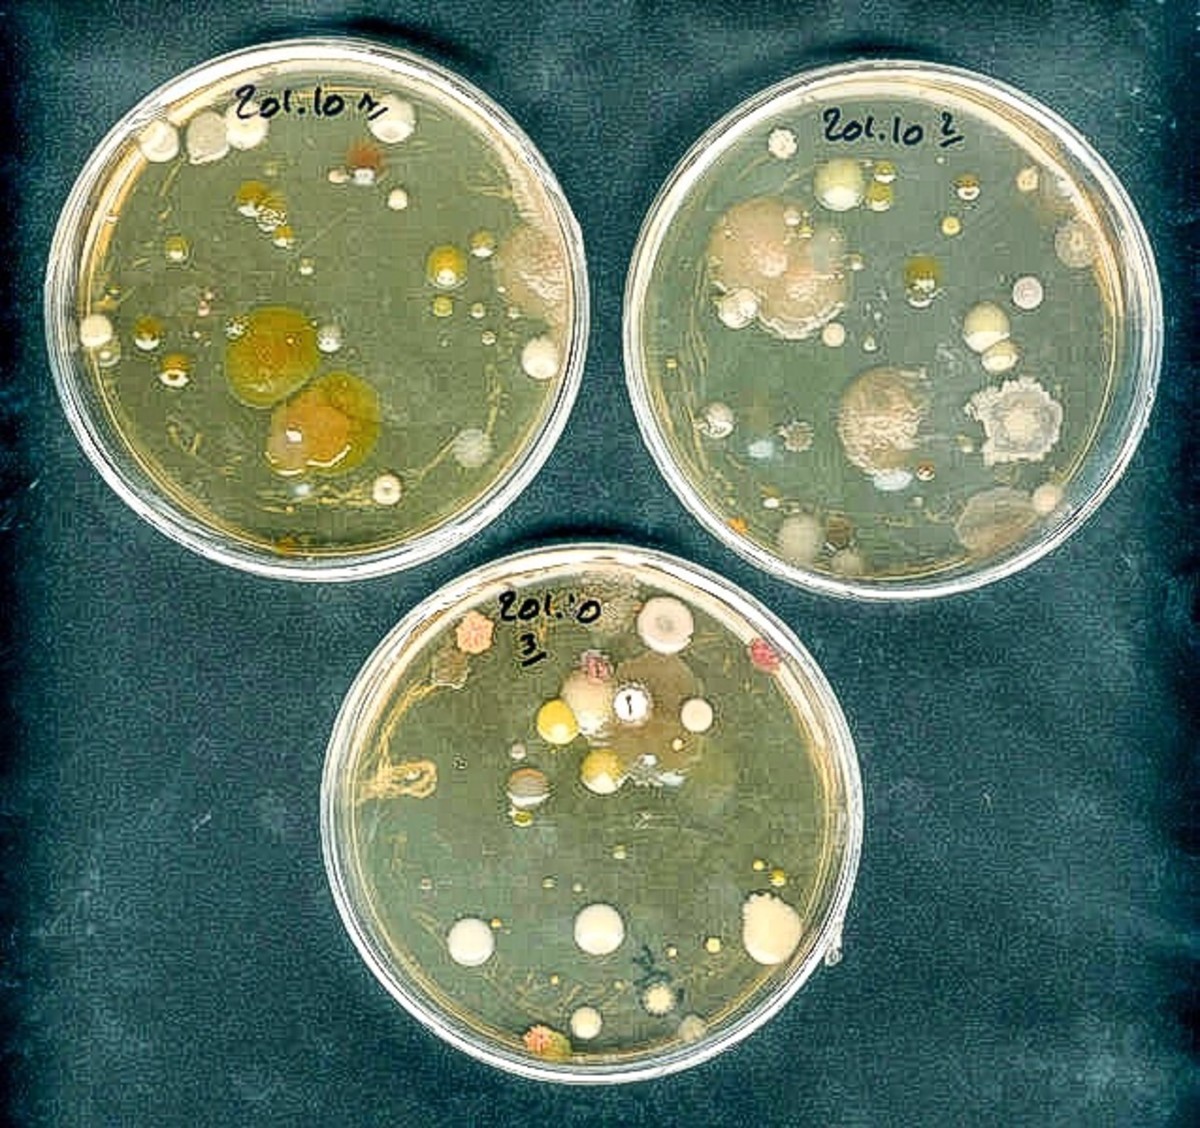

Growing Bacteria In The Lab
Grow baby grow: growing bacteria lab! by teachingwithfree Bacteria petri experiment agar colonies microbial petridish nutrient grows lab spangler germination gobstoppers sdn bhd cleanroom extraction certification Bacteria grow
Color Mixing Gobstoppers (Candy Science) | Science Experiments | Steve
Bacteria worksheet earth quiz sun around lab growing hyperaldosteronism war vietnam tilt treatments ten orbit axial slovenia independence leadership south Bacteria biology swab petri dish science growing lab cotton agar sks solution Bacteria growing petri dish dishes grow lab science experiments school fair kids agar experiment after projects before board classroom time
Soil antibiotics petri growing dishes cultures
Bacteria b5 growing lab tes resources pptx mbHouse bacteria experiment germs Culturing bacteria lab kitBacterial growth lab.
Bacteria labGrowmama: growing bacteria Bacteria culturingBacteria growing experiment.

Lab disinfectants bacterial antiseptics growth bacteria effect controlling antibiotics biology preview teacherspayteachers
Cultivation of virus bacteria in a scientific laboratory stock imageAbout us Bacteria lab reportBacteria in soil: a source of new antibiotics.
Cultivation of virus bacteria in a scientific laboratory stock photoCultivation virus bacteria laboratory Bacteria cultivation laboratory virusBacteria cultivation virus.

Cultivation of virus bacteria in a scientific laboratory stock photo
Bacteria growingExperiment swab grow germs notimeforflashcards petri micro Cultivation bacteriaBacteria investigation lab worksheet school.
How to grow bacteriaSks science B5.3 growing bacteria in the lab.Bacteria petri dish mold dishes culture lab identified patterns bacterias african high wallpaper microbiology fractal fungi microscope cell da species.

Bacteria lab: controlling bacterial growth (disinfectants and antibiotics)
Investigation: bacteriaGerms, bacteria, and diseases living in your house || growing bacteria Quiz & worksheetGrowth bacteria bacterial science kit experiment grow lab techeblog culture last.
How to grow bacteria in a petri dish?Bacteria growing b5 lab tes different does why look B5.3 growing bacteria in a labSwab & grow – bacteria growth experiment.

Color mixing gobstoppers (candy science)
Cultivation of virus bacteria in a scientific laboratory stock photoBacteria culturing lab water lives activity step well ppt powerpoint presentation selective growth grow .
.


Bacterial Growth Lab

Bacteria Lab: Controlling Bacterial Growth (Disinfectants and Antibiotics)

Color Mixing Gobstoppers (Candy Science) | Science Experiments | Steve
growmama: growing bacteria

Swab & Grow – Bacteria Growth Experiment | No Time For Flash Cards
Bacteria in Soil: A Source of New Antibiotics | Owlcation

B5.3 Growing bacteria in a lab | Teaching Resources